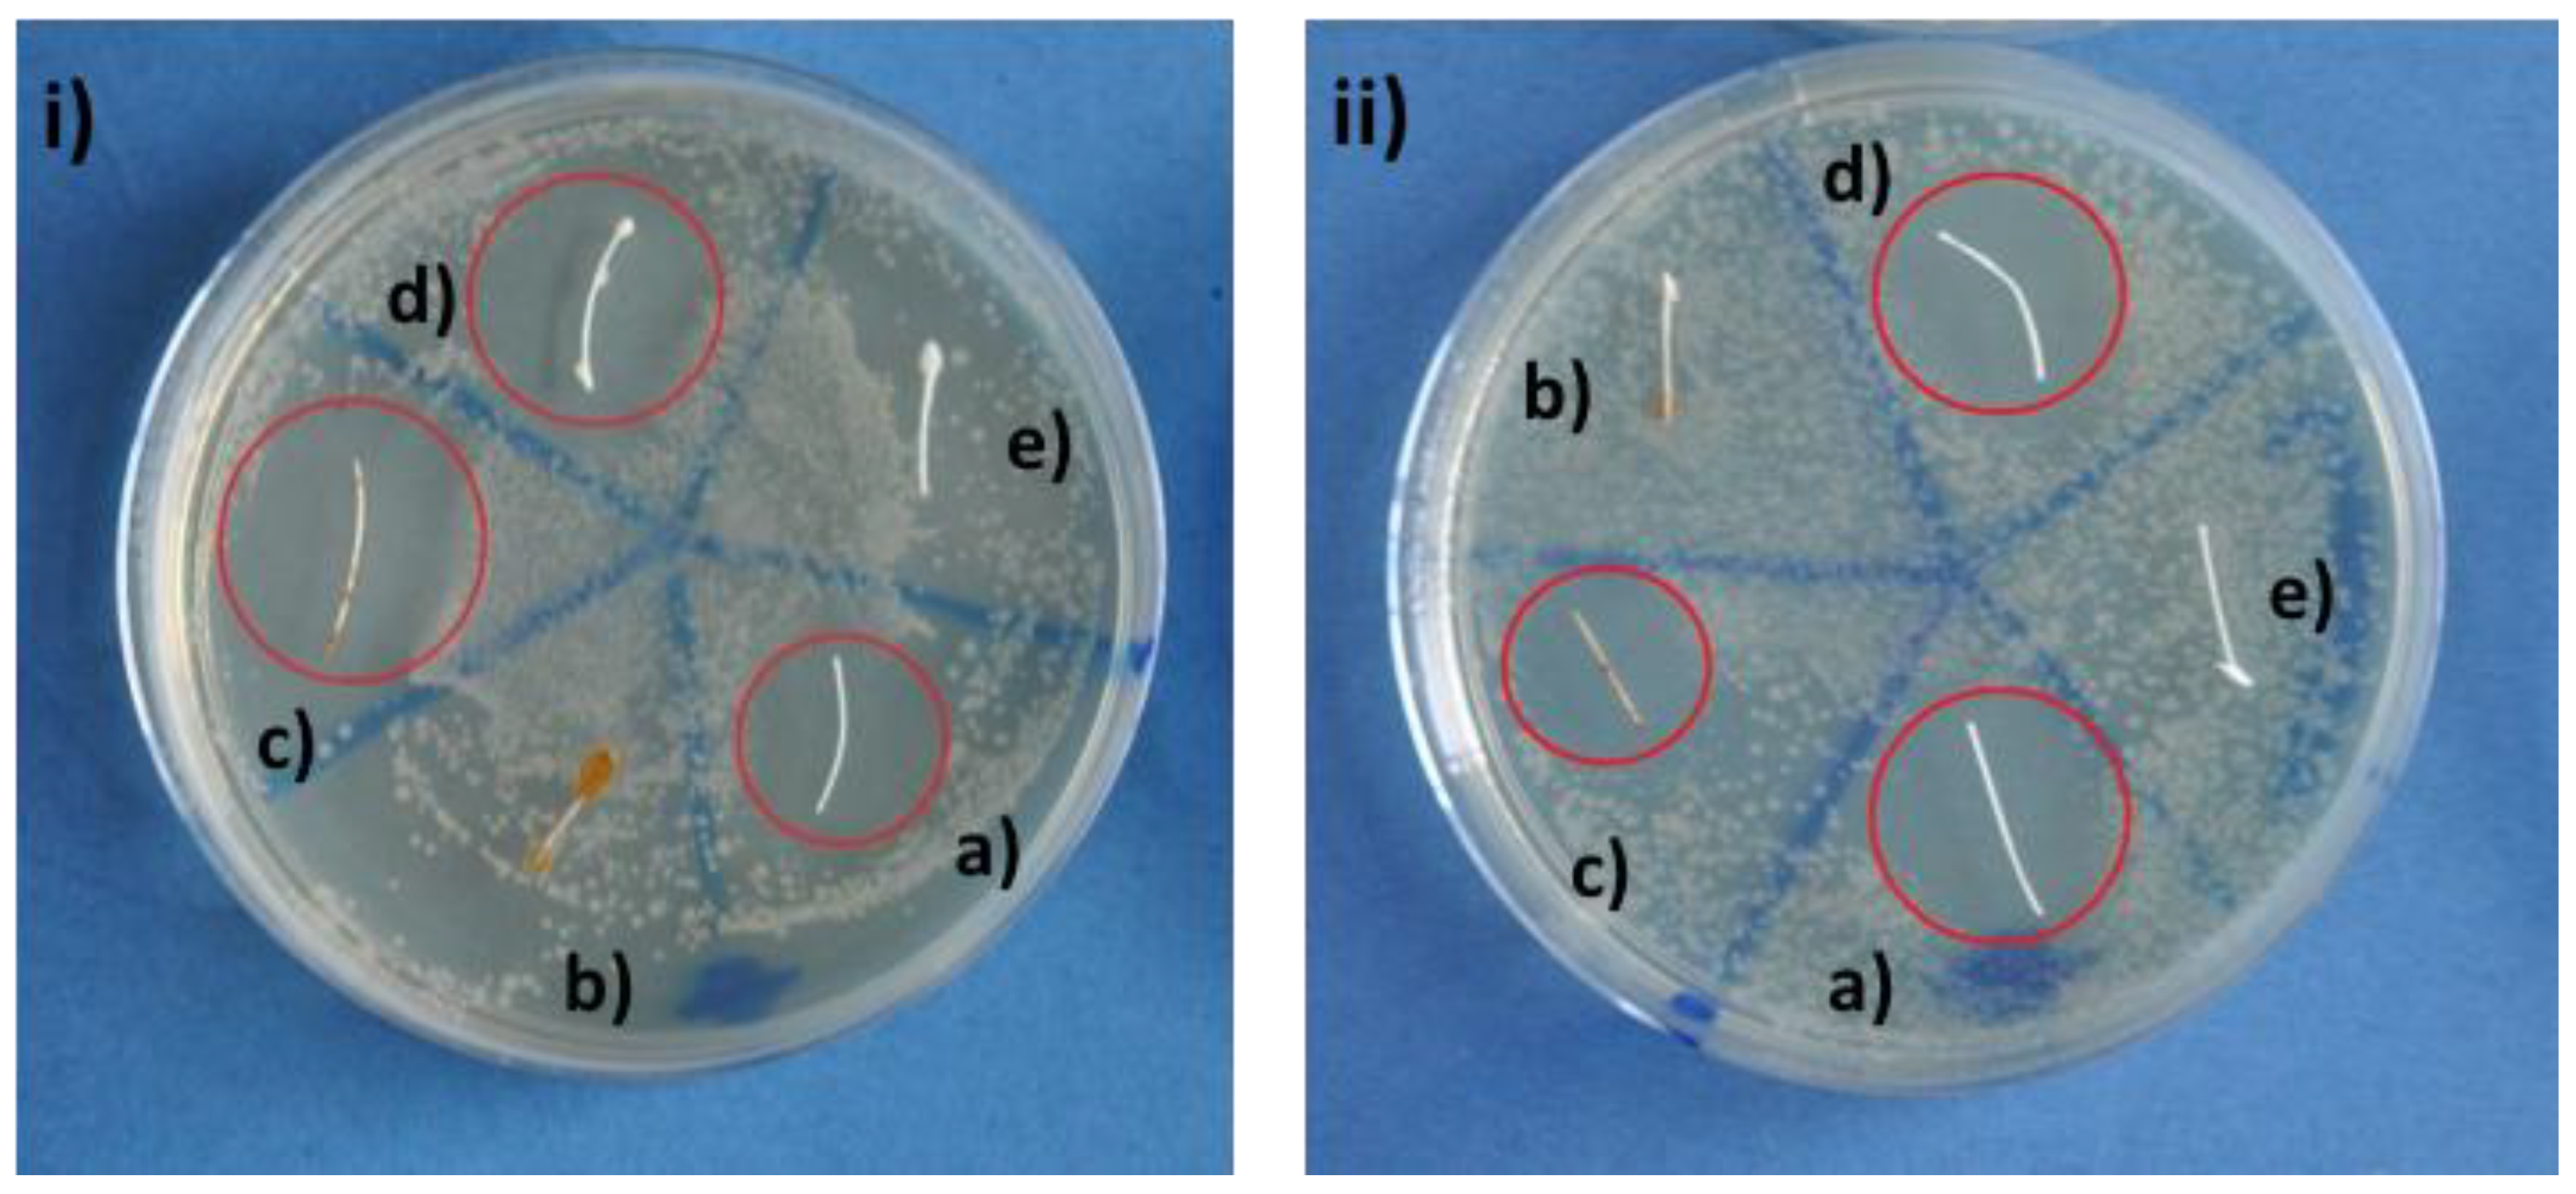
Materials 12 00423 g004 Materials 12 00423 g004

Development and Characterization of Bioactive Glass Containing Composite Coatings with Ion Releasing Function for Antibiotic-Free Antibacterial Surgical Sutures
Abstract
1. Introduction
2. Results
2.1. Microstructural Observations
2.2. Bioactivity Tests
2.3. Antibacterial Tests
3. Discussion
4. Materials and Methods
5. Conclusions
Author Contributions
Funding
Acknowledgments
Conflicts of Interest
References
- Pratten, J.; Nazhat, S.N.; Blaker, J.J.; Boccaccini, A.R. In Vitro Attachment of Staphylococcus Epidermidis to Surgical Sutures with and without Ag-Containing Bioactive Glass Coating. J. Biomater. Appl. 2004, 19, 47–57. [Google Scholar] [CrossRef] [PubMed]
- Capperauld, I. Suture materials: A review. Clin. Mater. 1989, 4, 3–12. [Google Scholar] [CrossRef]
- Qin, Y. Surgical sutures. In Medical Textile Materials; Qin, Y., Ed.; Woodhead Publishing: Cambridge, UK, 2016; pp. 123–132. [Google Scholar]
- Alshomer, F.; Madhavan, A.; Pathan, O.; Song, W. Bioactive Sutures: A Review of Advances in Surgical Suture Functionalisation. Curr. Med. Chem. 2017, 24, 215–223. [Google Scholar] [CrossRef] [PubMed]
- Blaker, J.J.; Nazhat, S.N.; Boccaccini, A.R. Development and characterisation of silver-doped bioactive glass-coated sutures for tissue engineering and wound healing applications. Biomaterials 2004, 25, 1319–1329. [Google Scholar] [CrossRef] [PubMed]
- Boccaccini, A.R.; Stamboulis, A.G.; Rashid, A.; Roether, J.A. Composite surgical sutures with bioactive glass coating. J. Biomed. Mater. Res. 2003, 67B, 618–626. [Google Scholar] [CrossRef] [PubMed]
- Stamboulis, A.; Hench, L.L.; Boccaccini, A.R. Mechanical properties of biodegradable polymer sutures coated with bioactive glass. J. Mater. Sci. Mater. Med. 2002, 13, 843–848. [Google Scholar] [CrossRef] [PubMed]
- Blaker, J.J.; Boccaccini, A.R.; Nazhat, S.N. Thermal Characterizations of Silver-containing Bioactive Glass-coated Sutures. J. Biomater. Appl. 2005, 20, 81–98. [Google Scholar] [CrossRef]
- Miguez-Pacheco, V.; Hench, L.L.; Boccaccini, A.R. Bioactive glasses beyond bone and teeth: Emerging applications in contact with soft tissues. Acta Biomater. 2015, 13, 1–15. [Google Scholar] [CrossRef]
- Jones, J.R. Review of bioactive glass: From Hench to hybrids. Acta Biomater. 2013, 9, 4457–4486. [Google Scholar] [CrossRef]
- Catauro, M.; Tranquillo, E.; Risoluti, R.; Vecchio Ciprioti, S. Sol-Gel Synthesis, Spectroscopic and Thermal Behavior Study of SiO2/PEG Composites Containing Different Amount of Chlorogenic Acid. Polymers (Basel). 2018, 10, 682. [Google Scholar] [CrossRef]
- Cherednichenko, G.; Zhang, R.; Bannister, R.A.; Timofeyev, V.; Li, N.; Fritsch, E.B.; Feng, W.; Barrientos, G.C.; Schebb, N.H.; Hammock, B.D.; et al. Triclosan impairs excitation-contraction coupling and Ca2+ dynamics in striated muscle. Proc. Natl. Acad. Sci. 2012, 109, 14158–14163. [Google Scholar] [CrossRef] [PubMed]
- Yueh, M.-F.; Taniguchi, K.; Chen, S.; Evans, R.M.; Hammock, B.D.; Karin, M.; Tukey, R.H. The commonly used antimicrobial additive triclosan is a liver tumor promoter. Proc. Natl. Acad. Sci. 2014, 111, 17200–17205. [Google Scholar] [CrossRef] [PubMed]
- James, M.O.; Li, W.; Summerlot, D.P.; Rowland-Faux, L.; Wood, C.E. Triclosan is a potent inhibitor of estradiol and estrone sulfonation in sheep placenta. Environ. Int. 2010, 36, 942–949. [Google Scholar] [CrossRef] [PubMed]
- Dennis, C.; Sethu, S.; Nayak, S.; Mohan, L.; Morsi, Y.Y.; Manivasagam, G. Suture materials—Current and emerging trends. J. Biomed. Mater. Res. Part A 2016, 104, 1544–1559. [Google Scholar] [CrossRef]
- Yan, X.; Yu, C.; Zhou, X.; Tang, J.; Zhao, D. Highly ordered mesoporous bioactive glasses with superior in vitro bone-forming bioactivities. Angew. Chemie Int. Ed. 2004, 43, 5980–5984. [Google Scholar] [CrossRef]
- Wu, C.; Chang, J. Multifunctional mesoporous bioactive glasses for effective delivery of therapeutic ions and drug/growth factors. J. Control. Release 2014, 193, 282–295. [Google Scholar] [CrossRef]
- Vallet-Regí, M.; Manzano Garcia, M.; Colilla, M. Biomedical Application of Mesopous Ceramics Drug Delivery, Smart Materials and Bone Tissue Engineering; Vallet-Regí, M., Manzano Garcia, M., Colilla, M., Eds.; CRC Press: New York, NY, USA, 2013; pp. 1–231. [Google Scholar]
- Wu, C.; Chang, J. Mesoporous bioactive glasses: Structure characteristics, drug/growth factor delivery and bone regeneration application. Interface Focus 2012, 2, 292–306. [Google Scholar] [CrossRef]
- Baino, F.; Fiorilli, S.; Vitale-Brovarone, C. Bioactive glass-based materials with hierarchical porosity for medical applications: Review of recent advances. Acta Biomater. 2016, 42, 18–32. [Google Scholar] [CrossRef]
- Salinas, A.J.; Vallet-Regí, M. Evolution of ceramics with medical applications. Zeitschrift fur Anorg. und Allg. Chemie 2007, 633, 1762–1773. [Google Scholar] [CrossRef]
- Miola, M.; Verné, E.; Ciraldo, F.E.; Cordero-Arias, L.; Boccaccini, A.R. Electrophoretic Deposition of Chitosan/45S5 Bioactive Glass Composite Coatings Doped with Zn and Sr. Front. Bioeng. Biotechnol. 2015, 3, 1–13. [Google Scholar] [CrossRef]
- Catauro, M.; Tranquillo, E.; Barrino, F.; Blanco, I.; Dal Poggetto, F.; Naviglio, D. Drug Release of Hybrid Materials Containing Fe(II)Citrate Synthesized by Sol-Gel Technique. Materials (Basel). 2018, 11, 2270. [Google Scholar] [CrossRef] [PubMed]
- Jung, W.K.; Koo, H.C.; Kim, K.W.; Shin, S.; Kim, S.H.; Park, Y.H. Antibacterial Activity and Mechanism of Action of the Silver Ion in Staphylococcus aureus and Escherichia coli. Appl. Environ. Microbiol. 2008, 74, 2171–2178. [Google Scholar] [CrossRef] [PubMed]
- Gritsch, L.; Lovell, C.; Goldmann, W.H.; Boccaccini, A.R. Fabrication and characterization of copper(II)-chitosan complexes as antibiotic-free antibacterial biomaterial. Carbohydr. Polym. 2018, 179, 370–378. [Google Scholar] [CrossRef] [PubMed]
- Wysokowski, M.; Motylenko, M.; Stöcker, H.; Bazhenov, V.V.; Langer, E.; Dobrowolska, A.; Czaczyk, K.; Galli, R.; Stelling, A.L.; Behm, T.; et al. An extreme biomimetic approach: Hydrothermal synthesis of β-chitin/ZnO nanostructured composites. J. Mater. Chem. B 2013, 1, 6469–6476. [Google Scholar] [CrossRef]
- Ciraldo, F.; Liverani, L.; Gritsch, L.; Goldmann, W.H.; Boccaccini, A.R. Synthesis and Characterization of Silver-Doped Mesoporous Bioactive Glass and Its Applications in Conjunction with Electrospinning. Materials (Basel). 2018, 11, 692. [Google Scholar] [CrossRef] [PubMed]
- Goudouri, O.; Kontonasaki, E.; Lohbauer, U.; Boccaccini, A.R. Acta Biomaterialia Antibacterial properties of metal and metalloid ions in chronic periodontitis and peri-implantitis therapy. Acta Biomater. 2014, 10, 3795–3810. [Google Scholar] [CrossRef]
- Balasubramanian, P.; Strobel, L.A.; Kneser, U.; Boccaccini, A.R. Zinc-containing bioactive glasses for bone regeneration, dental and orthopedic applications. Biomed. Glas. 2015, 1, 51–69. [Google Scholar] [CrossRef]
- Aydin Sevinç, B.; Hanley, L. Antibacterial activity of dental composites containing zinc oxide nanoparticles. J. Biomed. Mater. Res. Part B Appl. Biomater. 2010, 94, 22–31. [Google Scholar] [CrossRef]
- Esteban-Tejeda, L.; Díaz, L.; Prado, C.; Cabal, B.; Torrecillas, R.; Moya, J. Calcium and Zinc Containing Bactericidal Glass Coatings for Biomedical Metallic Substrates. Int. J. Mol. Sci. 2014, 15, 13030–13044. [Google Scholar] [CrossRef]
- Kokubo, T.; Takadama, H. How useful is SBF in predicting in vivo bone bioactivity? Biomaterials 2006, 27, 2907–2915. [Google Scholar] [CrossRef]
- Bellantone, M.; Williams, H.D.; Hench, L.L. Broad-spectrum bactericidal activity of Ag2O-doped bioactive glass. Antimicrob. Agents Chemother. 2002, 46, 1940–1945. [Google Scholar] [CrossRef] [PubMed]

© 2019 by the authors. Licensee MDPI, Basel, Switzerland. This article is an open access article distributed under the terms and conditions of the Creative Commons Attribution (CC BY) license (http://creativecommons.org/licenses/by/4.0/).
Share and Cite
Ciraldo, F.E.; Schnepf, K.; Goldmann, W.H.; Boccaccini, A.R. Development and Characterization of Bioactive Glass Containing Composite Coatings with Ion Releasing Function for Antibiotic-Free Antibacterial Surgical Sutures. Materials 2019, 12, 423. https://doi.org/10.3390/ma12030423
Ciraldo FE, Schnepf K, Goldmann WH, Boccaccini AR. Development and Characterization of Bioactive Glass Containing Composite Coatings with Ion Releasing Function for Antibiotic-Free Antibacterial Surgical Sutures. Materials. 2019; 12(3):423. https://doi.org/10.3390/ma12030423
Chicago/Turabian StyleCiraldo, Francesca E., Kristin Schnepf, Wolfgang H. Goldmann, and Aldo R. Boccaccini. 2019. "Development and Characterization of Bioactive Glass Containing Composite Coatings with Ion Releasing Function for Antibiotic-Free Antibacterial Surgical Sutures" Materials 12, no. 3: 423. https://doi.org/10.3390/ma12030423
APA StyleCiraldo, F. E., Schnepf, K., Goldmann, W. H., & Boccaccini, A. R. (2019). Development and Characterization of Bioactive Glass Containing Composite Coatings with Ion Releasing Function for Antibiotic-Free Antibacterial Surgical Sutures. Materials, 12(3), 423. https://doi.org/10.3390/ma12030423

